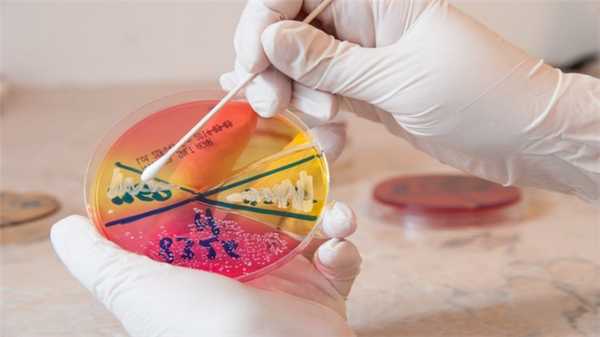
Когда золотистый стафилококк вызывает болезнь?

Инфекции золотистого стафилококка (Staphylococcus aureus): диагностика, лечение, профилактика
Добавил пользователь Alex Обновлено: 08.01.2026
Анализ на золотистый стафилококк — посев биологического материала на питательные среды для идентификации бактерии и её количества. В норме ответ должен быть отрицательный. Клинические проявления стафилококковой инфекции неспецифичны, поэтому анализ на стафилококк позволяет исключить другие заболевания со сходными симптомами, определиться с тактикой лечения. Для исследования используют разный биологический материал: отделяемое из урогенитального тракта, зева, носа, раневой поверхности, мочу, кал, кровь, грудное молоко.
Поликлиника Отрадное предлагает широкий спектр лабораторных анализов для выявления золотистого стафилококка.
Все исследования проводят на современных автоматических анализаторах, что обеспечивает высокое качество, достоверность и быстроту получения результатов.
Что такое золотистый стафилококк
Золотистый стафилококк — грамположительная бактерия из рода Стафилококков. Около 40% населения — носители этой бактерии. При неблагоприятных условиях инфекция активизируется, выделяет токсины, которые нарушают жизнедеятельность клеток, снижают защитные свойства иммунной системы.
К активизации стафилококковой инфекции предрасполагает местное и общее переохлаждение, регулярные стрессовые ситуации, алкогольная интоксикация, курение, хронический недосып, употребление просроченных молочных и кисломолочных продуктов.

Золотистый стафилококк вызывает широкий спектр заболеваний, начиная с аллергических реакций, кожных инфекций до смертельно-опасных состояний: менингита, остеомиелита, пневмонии, эндокардита. Сложность заключается в том, что стафилококк выживает в самых неблагоприятных условиях, устойчив к действию многих антибактериальных препаратов, высокой температуры. Это одна из самых частых бактерий, которой заражаются после посещения медицинских учреждений, операций.
Справка! Свое название золотистый стафилококк получил благодаря внешнему виду: в отличие от большей части бактерий, которые бесцветны под микроскопом, он имеет желтый цвет из-за наличия пигмента каротиноида.
В группу риска заражения золотистым стафилококком входят:
- беременные и кормящие,
- лица преклонного возраста,
- новорожденные,
- сотрудники медицинских учреждений,
- лица с ослабленным иммунитетом,
- пациенты с сахарным диабетом, онкологическими заболеваниями, ВИЧ-инфекциями.
Основные пути передачи — воздушно-капельный, контактный, гемоконтактный (с кровью).
Типы анализов на выявление стафилококка
Попадая в организм бактерия начинает размножаться, что проявляется клиническими симптомами, которые, в зависимости от места колонизации стафилококка, могут быть похожи на другие заболевания. Для того, чтобы свести диагноз к единственной вероятной болезни, в комплексное обследование включают анализ на золотистый стафилококк.
Исследование востребовано в гастроэнтерологии, педиатрии, отоларингологии, гинекологии, урологии, эндокринологии, дерматологии, кардиологии, акушерстве, нефрологии, ревматологии, хирургии. При небольшом содержании бактерии в биологическом материале (до 10³) фармакотерапию не назначают.
Посев мазка из зева и носоглотки

Исследование микрофлоры слизистой оболочки рото- и носоглотки даёт возможность выявить и идентифицировать стафилококковую инфекцию, её количество, определить чувствительность к антибактериальным препаратам.
Анализ проводят при наличии:
- хронического тонзиллита,
- дифтерии,
- скарлатины,
- при подозрении на ревматизм,
- частых ОРВИ.
Бакпосев назначают при жалобах на постоянный насморк и заложенность носа, беспричинную непроходящую боль в горле, субфебрильную температуру.
Сбор биоматериал преимущественно проводят в утреннее время натощак. Перед сдачей анализа нельзя чистить зубы, есть и пить. За 24-36 часов не используют противовирусные или антибактериальные препараты.
Микроскопическое исследование мазка из влагалища
При микроскопическом исследовании отделяемого из урогенитального тракта определяют состояние микрофлоры, наличие воспалительных процессов, бактерий и их количество, антибиотикорезистентность.
Анализ на золотистый стафилококк в гинекологии назначают при плановых гинекологических осмотрах, в период беременности, при подозрении на инфекционные заболевания мочеполовой системы.
Исследование требует специальной подготовки пациента:
- За 2-3 дня прекратить применение вагинальных свечей.
- За 36 часов ограничить половой контакт, спринцевания.
- Накануне анализа разрешается только туалет наружных половых органов.
- Минимум за два часа не рекомендовано мочиться.
Наиболее информативно исследование на 5-7 день после менструального цикла. Во время менструации соскоб не берут.
Биохимический анализ крови на золотистый стафилококк
Кровь берут в утреннее время натощак до 11.00. Чтобы результаты исследования были информативными, необходимо соблюдать несколько правил:
- Не есть 8-10 часов.
- За два дня отказаться от алкоголя.
- Накануне ограничить жирную пищу, чай, кофе, кондитерские изделия.
- Избегать эмоционального, физического переутомления.
- За полчаса до процедуры не курить.
Если вы принимаете какие-либо препараты, об этом необходимо сообщить врачу.
Анализ мочи и кала
Исследование кала на стафилококк наиболее востребовано в педиатрии, гастроэнтерологии и эндокринологии. Анализ показан для подтверждения заболеваний органов пищеварительной системы, оценки функций печени и поджелудочной железы, при различных заболеваниях кожи, частых ОРВИ, аллергии.
Материал для исследования — кал после самостоятельной дефекации, при этом важно, чтобы в него не попала урина. Собирают в стерильный, герметично закрывающийся контейнер, и в течение суток перенаправляют в лабораторию. Собранный биоматериал хранят в холоде при температуре +4-8°С.
Важно! Перед сбором материала за три дня не используют ректальные суппозитории, слабительные средства и другие препараты, которые влияют на работу ЖКТ.

Анализ мочи — универсальное исследование при первичной диагностики инфекций, заболеваний пищеварительной, дыхательной, сердечно-сосудистой системы
Подготовка и сбор мочи:
- За 2 дня отменить прием мочегонных препаратов.
- За день исключить алкоголь, соль, продукты, которые окрашивают мочу.
- За 24 часа избегать физических нагрузок, стресса.
- Мочу собирать утром. После пробуждения тщательно обмыть наружные половые органы без гигиенической косметики, насухо вытереть. Первую порцию слить. Для исследования использовать среднюю порцию мочи
Женщины не производят сбор мочи во время менструального цикла и спустя 1-2 дня. Противопоказан анализ в течение нескольких дней после оперативных вмешательств на мочевом пузыре.
Где сдать анализ на золотистый стафилококк
Золотистый стафилококк

Золотистый стафилококк — это анаэробная бактерия округлой формы, один из представителей семейства стафилококков, который способен вырабатывать устойчивость к антибиотикам и антисептикам.
Золотистый стафилококк (Staphylococcus aureus) — один из представителей семейства стафилококков. Способен вырабатывать устойчивость к антибиотикам различных групп и антисептикам. Хорошо выживает в неблагоприятной среде: не теряет активности при высушивании, 12 часов может находиться под прямыми солнечными лучами, в течение 10 минут выдерживает температуру 100 °С, не погибает в этиловом спирте и перекиси водорода.
Но золотистый стафилококк уязвим перед обычной зелёнкой (раствором бриллиантового зелёного). Её можно использовать для подсушивания кожных проявлений стафилококковой инфекции, затем обрабатывать их антибактериальным препаратом.
Название «золотистый стафилококк» объясняется тем, что колонии бактерий под микроскопом выглядят как гроздья оранжевого или жёлтого цвета.
Заболевания, которые вызывает золотистый стафилококк
Золотистый стафилококк в норме может годами жить на коже и слизистых оболочках, в кишечнике человека, не причиняя вреда. Так, бактерия постоянно обитает в носоглотке примерно у 20% людей, эпизодически — у 60%.
Но в стрессовых ситуациях — при снижении иммунитета, после травмы или операции — золотистый стафилококк способен вызвать стафилококковую инфекцию.
Факторы риска развития стафилококковой инфекции:
- стресс;
- неправильное питание;
- гиповитаминоз (дефицит витаминов);
- авитаминоз (полное отсутствие одного или нескольких витаминов);
- приём гормональных препаратов, антибиотиков;
- дисбактериоз кишечника;
- несоблюдение правил личной гигиены;
- недоношенность ребёнка.
Симптомы инфекции, вызванной золотистым стафилококком
Стафилококковая инфекция проявляется по-разному — в зависимости от поражённого органа.
На коже возникают фолликулит (в народе — прыщи), фурункулы и карбункулы. У новорождённых может развиться «синдром ошпаренной кожи» — острое поражение, вызванное одним из токсинов стафилококка.

Если стафилококковая инфекция поражает органы дыхания, то возникают тонзиллит, бронхит, пневмония и плеврит. Если уши и нос — отит и синусит. Если затронуты костная и соединительная ткани — развиваются артрит и остеомиелит.
Опасна стафилококковая инфекция для нервной и сердечно-сосудистой систем. Она может привести к таким заболеваниям, как менингит, эндокардит, флебит.
Ещё одна достаточно распространённая стафилококковая болезнь — пищевая токсикоинфекция. Бактерии хорошо размножаются в продуктах — особенно в консервах, овощных и мясных салатах. В процессе размножения золотистые стафилококки выделяют токсин, который накапливается в пище и вызывает рвоту, диарею, боль в животе.
Стафилококковая инфекция на фоне выраженного иммунодефицита может привести к сепсису — генерализованной инфекции, так называемому заражению крови. Это опасное состояние сопровождается высокой температурой, интоксикацией, нарушением сознания.
В последние годы в мире выросло число заболеваний, вызванных устойчивыми к антибиотикам бактериями, в том числе золотистым стафилококком.
Самые опасные стафилококки — в больницах. Они вынуждены выживать в условиях постоянного применения антибиотиков и дезинфицирующих средств, поэтому выработали необычайную устойчивость. Именно «больничные» стафилококки могут привести к госпитальной инфекции — заболеванию, которое развивается в стационаре у пациентов, медицинских работников и (реже) у посетителей.
Золотистый стафилококк у новорождённых и детей
Стафилококковая инфекция, как правило, развивается у детей с ослабленным иммунитетом. Среди факторов риска — возраст (грудные дети болеют чаще и тяжелее), недостаток веса, состояние здоровья, несоблюдение правил гигиены.
Заразиться можно в родильном отделении, стационаре или при контакте с заражённым человеком.
Симптомы стафилококковой инфекции у детей
Общие симптомы стафилококковой инфекции у детей:
- повышенная температура,
- головная боль,
- рвота и тошнота,
- покраснение или, наоборот, бледность кожи,
- диарея,
- вздутие живота,
- высыпания на коже и слизистых оболочках — у детей они чаще возникают в носу и горле.
В зависимости от локализации инфекционного очага могут наблюдаться боль в ухе, в суставах, одышка, кашель, боль в горле, покраснение глаз и т. д.
Лечение золотистого стафилококка у детей
При лёгкой форме стафилококковой инфекции кожи, как правило, назначают местные антибиотики. Если они не помогают — добавляют антибиотики системного действия. При среднетяжёлых и тяжёлых формах сразу могут быть назначены полусинтетические пенициллины и цефалоспорины. Срок лечения зависит от тяжести заболевания.
При конъюнктивите назначают промывание глаз слабым раствором марганцовки и закапывание альбуцида.
При пищевой токсикоинфекции может быть показано промывание желудка и, при необходимости (так как диарея и рвота приводят к электролитным нарушениям), внутривенные инфузии солевых растворов (физраствор, глюкоза, регидрон).
Диагностика стафилококковой инфекции
Выявить стафилококковую инфекцию помогает лабораторная диагностика.
Самый распространённый метод диагностики — микроскопическое исследование. Оно позволяет выявить в образце золотистый стафилококк. В качестве биоматериала используют грудное молоко, мокроту, кал, ректальный соскоб, отделяемое из уха, соскоб из зева, носа и с конъюнктивы. Если есть подозрение на сепсис, назначают посев крови.
Биоматериал засевают на питательные среды — специальные смеси, на которых бактерии размножаются лучше всего. Дополнительно могут добавлять антибиотики в разных дозировках. Образец оставляют на некоторое время, затем рассматривают под микроскопом, чтобы выяснить, какая именно культура развилась и насколько. Эта информация помогает определить возбудителя и правильную дозировку лекарств.
Стафилококковая кишечная инфекция у детей

Бактерии, относящиеся к роду стафилококков, всегда живут вокруг нас. Иногда они не причиняют никакого вреда человеческому организму, но в ряде случаев могут вызвать инфекционные заболевания, при которых в воспалительный процесс вовлекаются различные органы и ткани. В этой статье мы поговорим о стафилококковой кишечной инфекции в детском возрасте.
Роль стафилококка в возникновении кишечных инфекций у детей

Стафилококк, попадающий в желудочно-кишечный тракт ребёнка, может вызывать инфекционный процесс, клиническая картина которого довольно-таки разнообразна. Всего различается три вида стафилококков, каждый из них может стать причиной болезни у ребёнка: золотистый, эпидермальный и сапрофитный стафилококк.
Отличительными особенностями данных бактерий является то, что они располагаются гроздьями в мазке, имеют форму шара, не обладают подвижностью, не могут образовывать споры, не имеют жгутиков.
Патогенность стафилококков обусловлена тем, что они выделяют несколько токсинов и ферментов, которые поражают ткани человека. Кроме того, эти бактерии очень устойчивы к влиянию на них средовых факторов, поэтому они долго остаются жизнеспособными на предметах, в продуктах питания и во внешней среде. Однако банальное кипячение и воздействие дезинфицирующих средств на них губительно.
Иногда кишечной инфекцией, ассоциированной с заражением стафилококком, болеют целыми семьями или группами (в организованных коллективах), но единичные случаи болезни тоже встречаются. Попадают опасные бактерии к ребёнку через рот. То, насколько выраженными будут симптомы, зависит от возраста детей и наличия у них выраженных проблем со здоровьем.
Как можно заразиться стафилококковой инфекцией?
Заразиться стафилококковой кишечной инфекцией можно от человека, который уже ею болен или является носителем бактерии (то есть, явных симптомов болезни у него нет, но он опасен для окружающих). Описана роль и домашних животных в распространении и передаче инфекции среди людей, но этот источник инфекции признан второстепенным.
Заразиться стафилококковой инфекцией можно по-разному: и в быту, и при контактах, и при разговоре, и с продуктами питания и др. Самыми опасными продуктами питания для детей и взрослых в отношении стафилококковой инфекции являются следующие: молоко и молочные продукты, кондитерские изделия, торты и пирожные с кремом.
Диарея, лихорадка и другие симптомы стафилококковой инфекции

Стафилококковая кишечная инфекция у детей протекает в разных формах: пищевая токсикоинфекция, энтерит, энтероколит. Скрытый период болезни продолжается от 8 часов до 3-5 дней.
- Пищевая токсикоинфекция (гастрит, гастроэнтероколит)
Такой формой болезни обычно заболевают дети старшего возраста. Уже в первые сутки болезни ребёнка беспокоит интоксикация и диарея. Стул жидкий и частый, в нем могут обнаруживаться примеси слизи и крови. В ряде случаев появляется геморрагическая сыпь (по типу мелких кожных кровоизлияний), она проходит у детей бесследно.
Если ребёнок будет вовремя осмотрен врачом, и он будет получать полноценное лечение, то уже через пару дней у него не останется и следа от интоксикации, а концу недели можно будет уже говорить о выздоровлении. Осложнения для данной формы болезни не характерны.
- Энтерит (воспаление тонкого кишечника) и энтероколит (воспаление и тонкого и толстого кишечника)
Эта форма инфекции может быть первичной (при непосредственном попаданий бактерий в пищеварительный тракт) и вторичной (то есть, развиться при попадании возбудителя из других воспалительных очагов). Чаще болеют дети раннего возраста.
Первичный энтерит и энтероколит чаще встречается у детей, которым уже исполнилось полгода. Причем многие дети находятся на искусственном или смешанном вскармливании. Попадают стафилококки в детский организм преимущественно с пищей. Но некоторые родители отмечают в самом начале болезни наличие катаральных явлений у ребёнка. Это может свидетельствовать о том, что возбудитель попал в кишечник из носоглотки.
Обычно дети болеют этой формой инфекции нетяжело, без осложнений. Главными симптомами являются диарея и боли в животе (беспокойство малыша). Выздоровление длится долго. В это время может периодически отмечаться неустойчивый стул малыша.
Свои особенности стафилококковой инфекции отмечаются у новорожденных. Они обычно заражаются опасными бактериями еще в роддоме, причем часто стафилококк они получают от матери. Симптомы разворачиваются к концу первого месяца жизни. На первый план выходит диарея, в стуле обнаруживаются примеси зелени, слизи, иногда крови. Болезненность живота, ложные позывы на дефекацию не характерны. Еще стоит обратить внимание на постоянную субфебрильную температуру у новорожденных, хотя для ее повышения нет явных оснований.
Вторичный энтероколит и энтерит у малышей развивается тогда, когда стафилококк попадает в кишечник с током крови из других очагов. Эта форма болезни тяжелая, ребёнок испытывает сильную интоксикацию. Симптомы со стороны кишечника (диарея, рвота и срыгивания) переплетаются с симптоматикой со стороны других органов.
Диагностика и лечение стафилококковой инфекции у детей

В диагностике стафилококковой инфекции у детей применяются следующие методы:
Стафилококк

Стафилококки — это бактерии круглой формы, способные жить и размножаться в бескислородной среде и создавать колонии, похожие под микроскопом на гроздья винограда. Золотистый, эпидермальный и сапрофитный стафилококк — возбудители инфекционных заболеваний.
Что такое стафилококк
Стафилококки — бактерии, которым не нужен кислород для жизни и размножения.
Всего известно около 40 видов стафилококков. Большинство из них безвредны для человека. Три вида — золотистый, эпидермальный и сапрофитный стафилококк — могут стать причиной инфекционных заболеваний.
- Сапрофитный стафилококк (S. saprophyticus) чаще всего обитает в области гениталий и мочеиспускательного канала (уретры). Может спровоцировать цистит, уретрит.
- Эпидермальный (S. epidermidis) селится на любых участках кожи и слизистых оболочках. Наиболее опасен для пациентов после операций, связанных с внутренним протезированием: стафилококк может попасть внутрь вместе с протезом (шунтом, клапаном) и спровоцировать эндокардит — воспаление внутренней оболочки сердца, суставные инфекции, воспаление мочевыводящих путей.
- Золотистый стафилококк (S. aureus) — наиболее агрессивный представитель своего рода. Проникнув во внутреннюю среду организма, он может вызвать воспалительный процесс в органах и тканях. Устойчив к антибиотикам и антисептикам. Хорошо выживает в неблагоприятной среде: не теряет активности при высушивании, 12 часов может находиться под прямыми солнечными лучами, в течение 10 минут выдерживает температуру 150 °С, не погибает в этиловом спирте и перекиси водорода.
Название «стафилококк» происходит от древнегреческих слов σταφυλή («гроздь винограда») и κόκκος («зерно, ягода»). Колония этих бактерий под микроскопом действительно похожа на виноградную кисть.
Как можно заразиться стафилококком
Есть несколько путей передачи стафилококка:
- Контактно-бытовой. Стафилококк может попасть в организм через заражённые предметы: дверные ручки, средства личной гигиены.
- Воздушно-капельный. Бактерия выделяется во внешнюю среду, когда заражённый человек кашляет, чихает и даже разговаривает.
- Пищевой. Стафилококк передаётся через сырую воду, загрязнённые продукты, непромытую посуду.
- Вертикальный. Ребёнок может заразиться стафилококком от матери во время родов.
Стафилококковое пищевое отравление можно получить, если съесть просроченный продукт, особенно йогурт, кефир, простоквашу.
Виды стафилококковых инфекций
Стафилококковая инфекция — группа гнойно-воспалительных заболеваний, вызванных патогенными штаммами бактерий.
Инфекции, связанные с прямым проникновением стафилококка в ткани и органы:
- локализованные кожные инфекции: ячмень, абсцессы, фурункулы, карбункулы, фолликулиты;
- диффузные кожные инфекции: вульгарное импетиго — гнойничковое заболевание кожи; целлюлит (гнойное воспаление подкожной жировой клетчатки), в том числе орбитальный целлюлит — воспаление тканей глаза за орбитальной перегородкой;
- инфекции внутренних органов и тканей: септический артрит — воспаление сустава; острый и хронический остеомиелит — воспаление костного мозга; сепсис; пневмония; менингит; эндокардит — воспаление внутренней оболочки сердца;
- другие инфекции: астма, ринит, синусит.
Токсикозы — состояния, вызванные стафилококковым токсином:
- гастроэнтерит (пищевое отравление) — воспаление желудка и тонкого кишечника;
- синдром стафилококкового токсического шока (СТШ);
- стафилококковый синдром ошпаренной кожи (ССОК) — заболевание, при котором на коже образуются пузыри с отслойкой эпидермиса.
Причины возникновения стафилококковых инфекций
У большинства людей сапрофитный, эпидермальный и золотистый стафилококк в норме входят в состав микрофлоры и никак себя не проявляют. Иммунная система замедляет рост бактерий и удерживает их численность в безопасных пределах.
Но из-за снижения иммунитета на фоне болезней, стресса, неправильного питания может развиться стафилококковая инфекция.
Группы риска по развитию стафилококковой инфекции:
- пациенты с иммунодефицитом, в том числе вызванным ВИЧ — вирусом иммунодефицита человека;
- пациенты с сахарным диабетом, эндокринными заболеваниями, хроническими бронхолёгочными болезнями (например, с бронхиальной астмой);
- пациенты с имплантированными протезами;
- пациенты, которые проходят лечение кортикоидами (стероидными гормонами), иммунодепрессантами (препаратами, искусственно угнетающими иммунитет);
- пациенты на диализе;
- новорождённые, дети в первые годы жизни (в среднем до 5 лет);
- беременные;
- люди старше 60 лет;
- курильщики, люди, злоупотребляющие алкоголем.
Симптомы стафилококковой инфекции у взрослых
Симптомы инфекции зависят от локализации колонии бактерий.
Стафилококковая инфекция кожи — наиболее распространённая форма заболевания. Основные проявления: узелки, пустулы, ссыхающиеся в корки. Более глубокие поражения: фурункул, карбункул или абсцесс кожи в виде болезненного узла, с последующим формированием полости, заполненной гноем.

Стафилококковое пищевое отравление связано с употреблением заражённых продуктов. Многие продукты служат питательной средой для бактерий, сохраняя при этом нормальный запах и вкус.
Как правило, через 2-8 часов после еды появляется тяжёлая тошнота, рвота, боль в животе, диарея.
Стафилококковая пневмония — не самое распространённое проявление стафилококковой инфекции, но она может развиться у пациентов, которые болеют или переболели гриппом, принимают кортикостероиды, иммунодепрессанты, а также у людей с хроническими бронхолёгочными заболеваниями.
Симптомы стафилококковой пневмонии:
- общее недомогание,
- выраженная интоксикация,
- высокая температура,
- озноб,
- одышка,
- болезненный кашель.

Стафилококковый эндокардит — воспаление внутренней оболочки сердца.
Симптомы бактериального эндокардита:
- слабость,
- одышка,
- лихорадка,
- плохой аппетит,
- потеря веса,
- озноб,
- бледность кожи и слизистых оболочек.
Если стафилококковый эндокардит не начать лечить вовремя, могут развиться осложнения: септический шок, эмболия (перекрытие просвета) сосудов сердца и головного мозга, сердечная недостаточность.
Стафилококковый артрит — воспалительное заболевание, которое часто развивается после операции на суставах и установки суставного протеза.
Местные проявления стафилококкового артрита: отёк и покраснение кожи в области поражённого сустава, резкая боль, ограничение движения.
Общие проявления стафилококкового артрита: повышенная температура, озноб, выраженная интоксикация. У детей встречается также тошнота и рвота.
Инфекционный артрит, вызванный золотистым стафилококком, может привести к разрушению хряща сустава за несколько дней.
Стафилококковая инфекция при беременности
Период беременности может сопровождаться снижением иммунитета и обострением хронических заболеваний — а это создаёт благоприятные условия для роста колоний стафилококков.
Сапрофитный стафилококк не считается особенно опасным для беременных женщин. Как правило, он локализуется в органах мочеполовой системы и почках и провоцирует развитие цистита, уретрита, пиелонефрита. Благодаря выраженной симптоматике, сапрофитного стафилококка достаточно легко обнаружить в бактериальном посеве и вовремя принять меры, чтобы не допустить дальнейшего развития инфекции и осложнений.
Эпидермальный стафилококк достаточно быстро распространяется по кровотоку и может проникнуть через плацентарный барьер от матери к плоду, приводя к нарушениям его роста и развития.
Золотистый стафилококк — самый опасный. Если он проникает во внутреннюю среду организма, может развиться сепсис, что приведёт к поражению нервной системы и внутренних органов эмбриона. Также заражение ребёнка стафилококком во время родов повышает риск развития у него инфекции кожи и мягких тканей.
Стафилококковая инфекция у детей
У новорождённых стафилококк вызывает ряд специфических заболеваний:
- Эксфолиативный дерматит Риттера — тяжёлое инфекционное поражение кожи новорождённых, при котором она краснеет, образуются пузыри.
- Синдром ошпаренной кожи — острое поражение кожного покрова, вызванное одним из токсинов стафилококка. Характеризуется покраснением, отслойкой эпидермиса с образованием пузырей, напоминает ожог II степени.
- Эпидемическая пузырчатка новорождённых — острое инфекционное заболевание, при котором на коже образуются пузыри, заполненные серозным содержимым, и лопаются даже при небольшом касании. Инфицированная жидкость попадает на кожу и провоцирует появление новых пузырей.
- Острый мастит — гнойно-воспалительное заболевание грудной железы. Обычно проявляется на 7-10-й день жизни ребёнка. Сопровождается уплотнением железы (обычно с одной стороны), повышением температуры до 39 С°.
В дошкольном и школьном возрасте инфицирование стафилококком может привести к развитию синусита, ринита, фарингита, бронхита и пневмонии.
Также достаточно распространены поражения кожи, причём у детей их может вызвать не только золотистый стафилококк, но и эпидермальный, сапрофитный — как правило, при иммунодефицитных состояниях.
К какому врачу обращаться
Лечением стафилококковой инфекции занимаются врачи-инфекционисты. Если нет точно поставленного диагноза, можно обратиться к терапевту или педиатру для обследования.
Какие анализы нужно сдать
Анализ на стафилококк берут из той зоны, в которой предположительно развивается инфекция.
Современные методы позволяют исследовать самые разные биоматериалы и биологические жидкости: грудное молоко, кал, мочу, мокроту, соскоб из зева, носа или с конъюнктивы, отделяемое из уха и раневое отделяемое.
Золотистый стафилококк: что делать, если ребенок — носитель стафилококка?

Золотистый стафилококк (Staphylococcus aureus) — это наиболее распространенный бактериальный возбудитель различных инфекций, начиная от фолликулита и фурункулеза и заканчивая опасными для жизни состояниями, например, сепсисом, глубокими абсцессами, пневмонией и инфекционным эндокардитом. Такая бактерия может колонизировать кожные покровы и слизистые оболочки, она отличается огромными адаптационными возможностями. Носительство золотистого стафилококка очень часто обнаруживается у детей дошкольного и младшего школьного возраста: в соответствии с данными статистики, такая картина выявляется у 20-50% маленьких пациентов.
Откуда берутся стафилококки в организме ребёнка?
У значительного количества детей золотистые стафилококки можно обнаружить в носоглотке или кале буквально в первые месяцы жизни. И подобные результаты анализов обычно повергают родителей в состояние шока, ведь кажется, что такая бактерия очень опасна, и ее нужно немедленно уничтожать. Но врачи предостерегают от необдуманных решений.
Известно, что в организме каждого взрослого человека обитает множество бактерий. Они находятся на слизистых оболочках, в пищеварительном тракте, на коже и пр. Когда ребёнок появляется на свет, его организм постепенно колонизируется бактериями и прочими организмами. Этот процесс начинается еще во время прохождения сквозь материнские родовые пути. Колонизация бактериями является абсолютно нормальным этапом в жизни малыша, она необходима для формирования здоровой микрофлоры. Встречи с потенциально опасными возбудителями помогают сформироваться крепкому иммунитету.
Практически все новорожденные уже в первые дни жизни (в роддоме) сталкиваются с золотистым стафилококком. Это достаточно коварная бактерия, которая является стойкой к разрушающим воздействиям внешней среды, многим антисептикам и антибиотикам. Золотистый стафилококк остается жизнеспособным при высушивании, может жить 12 часов под прямыми солнечными лучами и даже выдерживать температуру около 80° С на протяжении 30 минут. Тем не менее, такой возбудитель далеко не всегда вызывает болезнь — стафилококковую инфекцию. При нормальной работе иммунитета активность бактерий подавляется — они не могут размножаться. В такой ситуации золотистый стафилококк становится частью условно-патогенной микрофлоры. Как правило, носительство такой бактерии носит транзиторный характер: организм освобождается от стафилококка спустя некоторое время, впоследствии возможно заражение уже другими штаммами.
Когда золотистый стафилококк вызывает болезнь?
Золотистый стафилококк действительно может вызвать серьезные и даже смертельно опасные болезни. Но в то же время эта бактерия может присутствовать в организме на протяжении длительного времени (месяцами и даже годами), не причиняя ребёнку никакого вреда. Для возникновения болезни (стафилококковой инфекции) необходимы определенные условия, в частности, снижение сопротивляемости организма.
Если иммунитет ребёнка работает нормально, стафилококк не будет причинять носителю никакого беспокойства. Однако при ослабленности иммунной защиты опасная бактерия может проявить себя.
Что делать при носительстве стафилококка у ребёнка?
Современные педиатры придерживаются той точки зрения, что бессимптомное носительство золотистого стафилококка у детей не требует какого-либо лечения. Родителям малышей с такой проблемой не стоит паниковать, нужно лишь принимать общие меры по сохранению здоровья ребёнка. Это касается:
- соблюдения элементарных правил личной гигиены;
- здорового сбалансированного питания;
- правильного режима дня;
- организации оптимального микроклимата в детской комнате и всей квартире;
- регулярных прогулок на свежем воздухе;
- достаточной физической активности;
- профилактики общего переохлаждения и перегрева;
- своевременной санации микротравм кожи и пр.
Носительство стафилококка не является показанием для проведения направленного антибактериального лечения.
Санация носителей золотистого стафилококка

- аллергизацией организма ребёнка;
- возникновением антибиотик-ассоциированной диареи;
- выраженными дисбиотическими изменениями.
Что касается применения местных антибактериальных средств (чаще всего с этой целью используют мупироцин), то они дают лишь временный положительный эффект. В 2019 г. вышла статья американских ученых, которые провели исследование новорожденных детей, подвергавшихся санации мупироцином. Такое лекарство действительно помогло устранить золотистый стафилококк, но у многих малышей его обнаружили повторно еще до выписки из больницы.
Ребёнку с носительством золотистого стафилококка показана обязательная санация в случае госпитализации, например, для проведения оперативного вмешательства. Это объясняется тем, что носитель опасной бактерии может быть опасен для других пациентов, кроме того, стафилококковая инфекция может развиться у него самого. Однако в то же время недавнее исследование итальянских ученых (2018 г., Department of Surgical and Biomedical Sciences, Universitа degli Studi di Perugia) показало, что у детей с носительством золотистого стафилококка нет повышенного риска инфекции места оперативного вмешательства.
Также установлено, что инфицирование окружающих может произойти при высокой обсемененности носителя — если в 1 мл назального секрета присутствует более 10 млн бактерий. Поэтому необходимость санации при бессимптомном носительстве — это достаточно сомнительный вопрос.
Ребёнок проявляет беспокойство и жалуется на страшные сны? Не может сосредоточиться на занятии, волнуется и часто жалуется на больной живот? Наш тест поможет определить уровень тревожности у ребёнка и подскажет дальнейшую тактику поведения.
Читайте также:
- Показания для операции при переломе поясничного отдела позвоночника
- Замучила гипертония? Не лечите повышенное давление только таблетками
- Рекомендации по анализу рентгенограммы органов грудной клетки в аксиальной (лордотической) ПЗ проекции
- Уход после операции при невроме Мортона
- Поражения почек у больного раком
